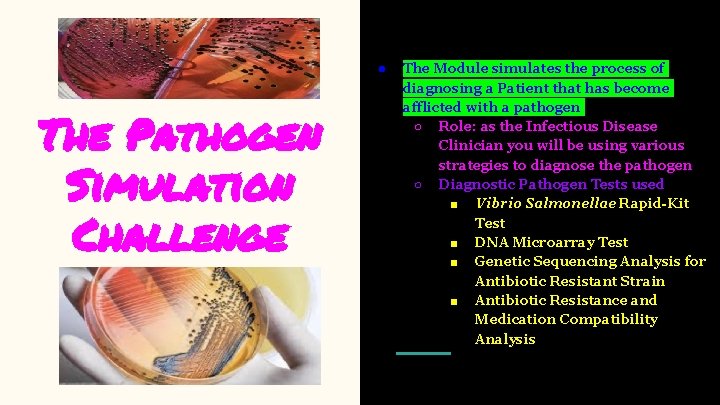
● The Pathogen Simulation Challenge The Module simulates the process of diagnosing a Patient

You Are What You Eat Unless What You

- Slides: 15
You Are What You Eat, Unless What You Eat Kills You! Javeshnev Aimee Rivera-Azua STEAM Coach/Coordinator School District of Palm Beach javeshnev. azua@gmail. com javeshnev. riveraazua@palmbeachschools. org
● The Pathogen Simulation Challenge The Module simulates the process of diagnosing a Patient that has become afflicted with a pathogen ○ Role: as the Infectious Disease Clinician you will be using various strategies to diagnose the pathogen ○ Diagnostic Pathogen Tests used ■ Vibrio Salmonellae Rapid-Kit Test ■ DNA Microarray Test ■ Genetic Sequencing Analysis for Antibiotic Resistant Strain ■ Antibiotic Resistance and Medication Compatibility Analysis
Focus Rationale ● targets the process of genetic variation that affects the evolution of pathogens and has led to antibiotic resistant strains that require compatibility assessments ● to expose our students to the variability of treating pathogens depending on type and antibiotic resistance of the pathogen
Salmonella Outbreak Epidemic Case
Targeted Audience ● Targeted Students ○ 8 th Grade ○ 9 th-12 th ○ College Level Undergraduate Students
Implementation Process ● Targeted Students ○ 8 th Grade / 9 th-12 th ■ Hands-on PBL facilitates lab ■ Required APA Lab ○ College Level Undergraduate Students ■ Blended learning model ■ Virtual Lab ■ Required APA
Marshmallow (Non-Resistant Strain Bacteria) & M&M (Resistant Strain Bacteria ) Lab
Genetic Sequencing
Graphing Results
Errors in Graphing
Suggested Changes & Clarifications ● Clarify that you start with 25 marshmallows and will only be removing from not adding to during each dose ● Clarify that m&m represents antibiotic resistant strain of bacteria; hard shell is the mutation that makes it more resistant to piercing toothpick (white blood cells/antibodies ● Clarify type of graph is a line graph due to continuous time ● Clarify /model how to find patterns in genetic sequences ● Can be used as remediation for chapters, can be also used as a reading & ELA reading strategies activity as well
References